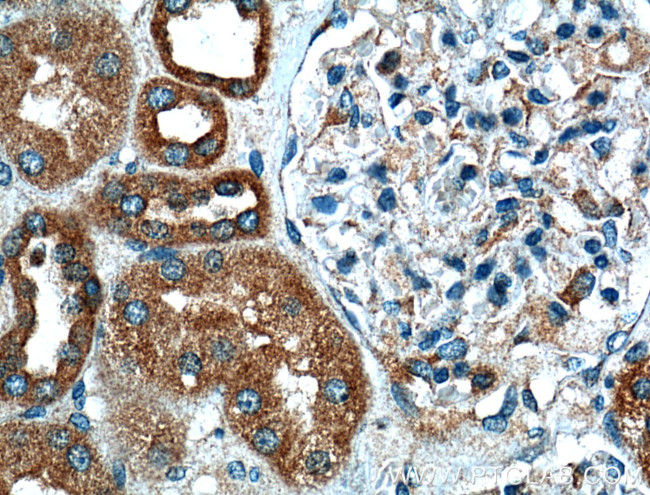
VDAC2 Antibody in Immunohistochemistry (Paraffin) (IHC (P))
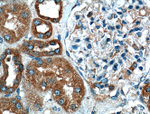
VDAC2 Antibody in Immunohistochemistry (Paraffin) (IHC (P))
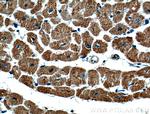
VDAC2 Antibody in Immunohistochemistry (Paraffin) (IHC (P))

Search
Proteintech
VDAC2 Monoclonal Antibody (1D8C11)
{{$productOrderCtrl.translations['antibody.pdp.commerceCard.promotion.promotions']}}
{{$productOrderCtrl.translations['antibody.pdp.commerceCard.promotion.viewpromo']}}
{{$productOrderCtrl.translations['antibody.pdp.commerceCard.promotion.promocode']}}: {{promo.promoCode}} {{promo.promoTitle}} {{promo.promoDescription}}. {{$productOrderCtrl.translations['antibody.pdp.commerceCard.promotion.learnmore']}}
产品信息
66388-1-IG
种属反应
已发表种属
宿主/亚型
分类
类型
克隆号
抗原
偶联物
形式
浓度
规格
纯化类型
保存液
内含物
保存条件
运输条件
靶标信息
This gene encodes a member of the voltage-dependent anion channel pore-forming family of proteins that are considered the main pathway for metabolite diffusion across the mitochondrial outer membrane. The encoded protein is also thought to be involved in the mitochondrial apoptotic pathway via regulation of BCL2-antagonist/killer 1 protein activity. Pseudogenes have been identified on chromosomes 1, 2, 12 and 21, and alternative splicing results in multiple transcript variants.
仅用于科研。不用于诊断过程。未经明确授权不得转售。
生物信息学
蛋白别名: B36-VDAC; epididymis secretory sperm binding protein; FLJ23841; Non-selective voltage-gated ion channel VDAC2; Outer mitochondrial membrane protein porin 2; RP11-375G3.1; unnamed protein product; VDAC-2; VDAC-6; VDAC2; voltage-dependent anion-selective channel protein 2; Voltage-dependent anion-selective channel protein 6
基因别名: mVDAC2; mVDAC6; POR; VDAC2; Vdac6
UniProt ID: (Human) P45880, (Mouse) Q60930, (Rat) P81155
Entrez Gene ID: (Human) 7417, (Mouse) 22334, (Rat) 83531